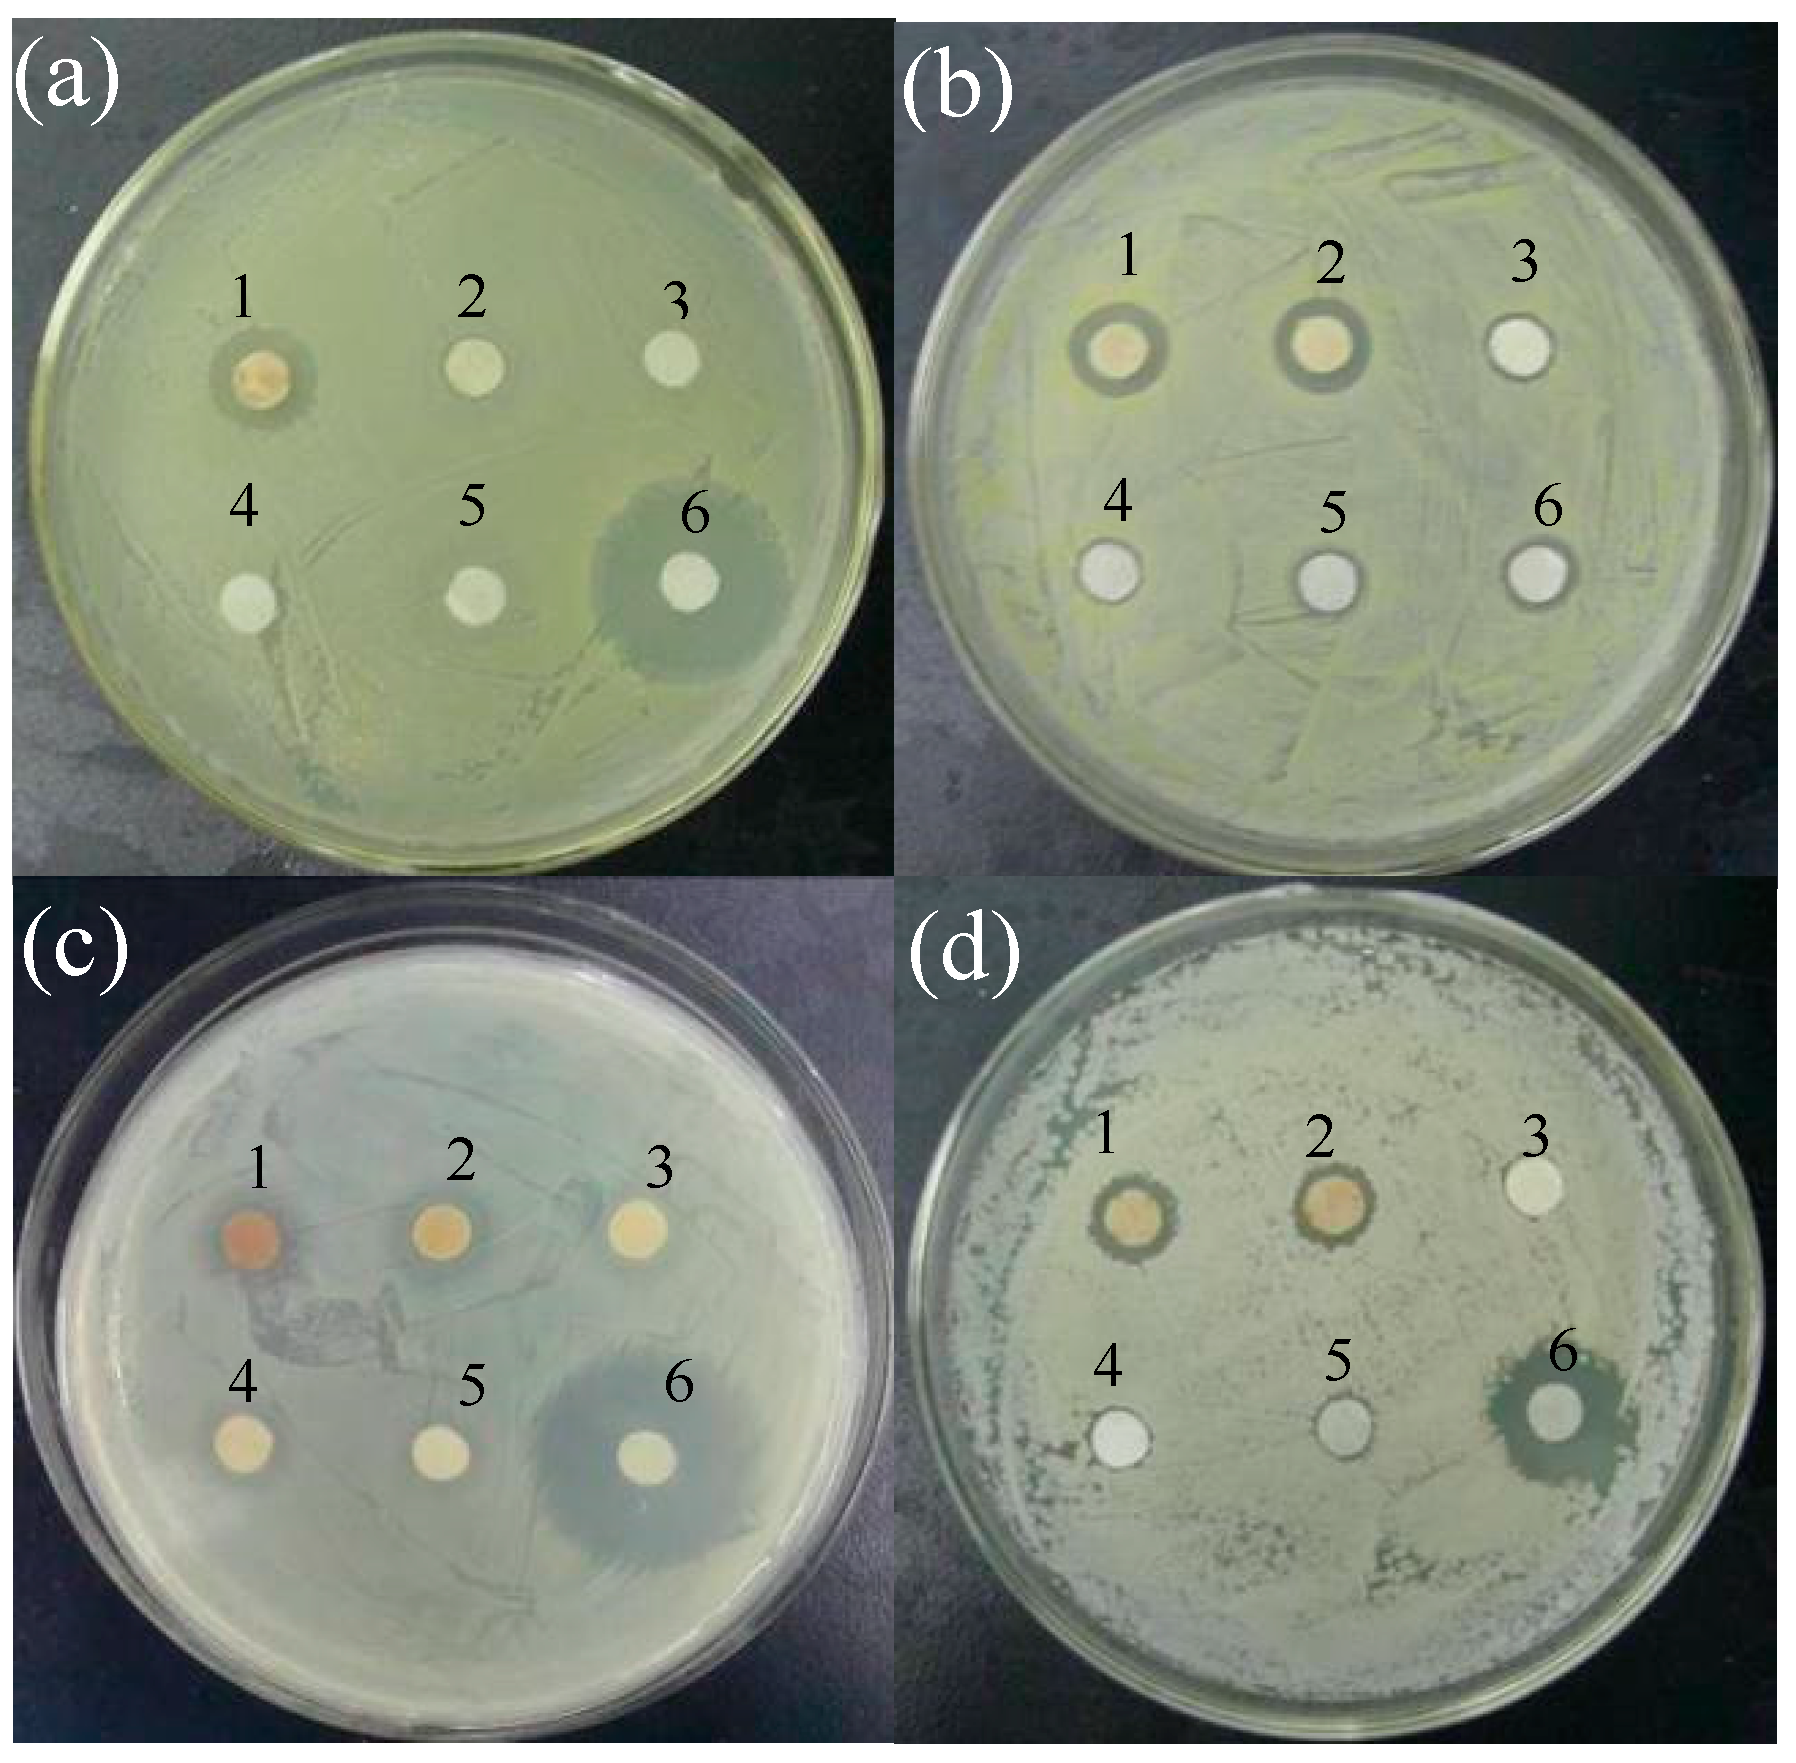

Biosynthesis of Silver Nanoparticles Using Taxus yunnanensis Callus and Their Antibacterial Activity and Cytotoxicity in Human Cancer Cells
Abstract
:1. Introduction
2. Results
2.1. The Synthesis of AgNPs
2.2. Characterization of AgNPs
2.3. Antibacterial Activity of AgNPs
2.4. Cytotoxicity Experiments
3. Discussion
4. Materials and Methods
4.1. Preparation of Callus Extracts of T. yunnanensis
4.2. Synthesis of AgNPs
4.3. Characterization of AgNPs
4.4. Antibacterial Activity
4.5. Cytotoxicity Experiments
4.5.1. Cell Culture
4.5.2. Cell Viability Assay
4.5.3. Flow Cytometry Analysis of Apoptosis
5. Conclusions
Supplementary Materials
Acknowledgments
Author Contributions
Conflicts of Interest
Abbreviations
| AgNPs | Silver nanoparticles |
| FTIR | Fourier transform infrared spectroscopy |
| MIC | Minimum inhibitory concentration |
| MTT | 3-(4,5-Dimethylthiazol-2-yl)-2,5-diphenyltetrazolium bromide |
| PBS | Phosphate buffered saline |
| ROS | Reactive oxygen species |
| TEM | Transmission electron microscopy |
| XRD | X-ray diffraction |
References
- Chernousova, S.; Epple, M. Silver as antibacterial agent: Ion, nanoparticle, and metal. Angew. Chem. Int. Ed. 2013, 52, 1636–1653. [Google Scholar] [CrossRef] [PubMed]
- Gutierrez, F.M.; Olive, P.L.; Banuelos, A.; Orrantia, E.; Nino, N.; Sanchez, E.M.; Ruiz, F.; Bach, H.; Gay, Y.A. Synthesis, characterization, and evaluation of antimicrobial and cytotoxic effect of silver and titanium nanoparticles. Nanomedicine 2010, 6, 681–688. [Google Scholar]
- Morones, J.R.; Elechiguerra, J.L.; Camacho, A.; Holt, K.; Kouri, J.B.; Ramírez, J.T.; Yacaman, M.J. The bactericidal effect of silver nanoparticles. Nanotechnology 2005, 16, 2346–2353. [Google Scholar] [CrossRef] [PubMed]
- Ghorbani, H.R.; Safekordi, A.A.; Attar, H.; Sorkhabadi, S.M.R. Biological and non-biological methods for silver nanoparticles synthesis. Chem. Biochem. Eng. Q. 2011, 25, 317–326. [Google Scholar]
- Park, Y.; Hong, Y.N.; Weyers, A.; Kim, Y.S.; Linhardt, R.J. Polysaccharides and phytochemicals: A natural reservoir for the green synthesis of gold and silver nanoparticles. IET Nanobiotechnol. 2011, 5, 69–78. [Google Scholar] [CrossRef] [PubMed]
- Thakkar, K.N.; Mhatre, S.S.; Parikh, R.Y. Biological synthesis of metallic nanoparticles. Nanomed. Nanotechnol. 2010, 6, 257–262. [Google Scholar] [CrossRef] [PubMed]
- Mude, N.; Ingle, A.; Gade, A.; Rai, M. Synthesis of silver nanoparticles using callus extract of Carica papaya—A first report. J. Plant Biochem. Biotechnol. 2009, 18, 83–86. [Google Scholar] [CrossRef]
- Hegazy, H.S.; Rabie, G.H.; Shaaban, L.D.; Raie, D.S. Extracellular synthesis of silver nanoparticles by callus of Medicago sativa. Life Sci. J. 2014, 11, 1211–1214. [Google Scholar]
- Barkat, M.A.; Mujeeb, M.; Samim, M.; Verma, S. Biosynthesis of silver nanoparticles using callus extract of Catharanthus roseus var. alba and assessment of its antimicrobial activity. Br. J. Pharm. Res. 2014, 4, 1591–1603. [Google Scholar] [CrossRef]
- Nabikhan, A.; Kandasamy, K.; Raj, A.; Alikunhi, N.M. Synthesis of antimicrobial silver nanoparticles by callus and leaf extracts from saltmarsh plant, Sesuvium portulacastrum L. Colloid Surface B 2010, 79, 488–493. [Google Scholar] [CrossRef] [PubMed]
- Ahmed, S.; Ahmad, M.; Swami, B.L.; Ikram, S. A review on plants extract mediated synthesis of silver nanoparticles for antimicrobial applications: A green expertise. J. Adv. Res. 2016, 7, 17–28. [Google Scholar] [CrossRef] [PubMed]
- Satyavani, K.; Gurudeeban, S.; Ramanathan, T.; Balasubramanian, T. Biomedical potential of silver nanoparticles synthesized from calli cells of Citrullus colocynthis (L.) Schrad. J. Nanobiotechnol. 2011, 9, 2–8. [Google Scholar]
- Nguyen, N.T.; Banskota, A.H.; Tezuka, Y.; Nobukawa, T.; Kadota, S. Diterpenes and sesquiterpenes from the bark of Taxus yunnanensis. Phytochemistry 2003, 64, 1141–1147. [Google Scholar]
- Luo, J.P.; Mu, Q.; Gu, Y.H. Protoplast culture and paclitaxel production by Taxus yunnanensis. Plant Cell Tissue Org. 1991, 59, 25–29. [Google Scholar] [CrossRef]
- Zhang, C.H.; Wu, J.Y.; He, G.Y. Effects of inoculum size and age on biomass growth and paclitaxel production of elicitor-treated Taxus yunnanensis cell cultures. Appl. Microbiol. Biotechnol. 2002, 60, 396–402. [Google Scholar] [PubMed]
- Wang, J.W.; Zheng, L.P.; Wu, J.Y.; Tan, R.X. Involvement of nitric oxide in oxidative burst, phenylalanine ammonia-lyase activation and taxol production induced by low-energy ultrasound in Taxus yunnanensis cell suspension cultures. Nitric Oxide 2006, 15, 351–358. [Google Scholar] [CrossRef] [PubMed]
- Zheng, L.P.; Zhang, Z.; Zhang, B.; Wang, J.W. Antifungal properties of Ag-SiO2 core-shell nanoparticles against phytopathogenic fungi. Adv. Mater. Res. 2012, 476–478, 814–818. [Google Scholar] [CrossRef]
- Mulvaney, P. Surface plasmon spectroscopy of nanosized metal particles. Langmuir 1996, 12, 788–800. [Google Scholar] [CrossRef]
- Wei, X.; Zhou, H.; Xu, L.; Luo, M.; Liu, H. Sunlight-induced biosynthesis of silver nanoparticles by animal and fungus biomass and their characterization. J. Chem. Technol. Biotechnol. 2014, 89, 305–311. [Google Scholar] [CrossRef]
- Shinozaki, Y.; Fukamiya, N.; Uchiyama, C.; Okano, M.; Tagahara, K.; Bastow, K.F.; Lee, K.H. Multidrug resistant cancer cells susceptibility to cytotoxic taxane diterpenes from Taxus yunnanensis and Taxus chinensis. Bioorg. Med. Chem. Lett. 2002, 12, 2785–2788. [Google Scholar] [CrossRef]
- Yin, Y.; Yu, R.; Yang, W.; Yuan, F.; Yan, C.; Song, L. Structural characterization and anti-tumor activity of a novel heteropolysaccharide isolated from Taxus yunnanensis. Carbohyd. Polym. 2010, 82, 543–548. [Google Scholar] [CrossRef]
- Yan, C.; Yin, Y.; Zhang, D.; Yang, W.; Yu, R. Structural characterization and in vitro antitumor activity of a novel polysaccharide from Taxus yunnanensis. Carbohyd. Polym. 2013, 96, 389–395. [Google Scholar] [CrossRef] [PubMed]
- Singla, A.K.; Garg, A.; Aggarwal, D. Paclitaxel and its formulations. Int. J. Pharm. 2002, 235, 179–192. [Google Scholar] [CrossRef]
- Yin, J.; Tezuka, Y.; Shi, L.; Nobukawa, M.; Nobukawa, T.; Kadota, S. In vivo anti-osteoporotic activity of isotaxiresinol, a lignan from wood of Taxus yunnanensis. Phytomedicine 2006, 13, 37–42. [Google Scholar] [CrossRef] [PubMed]
- Koyama, J.; Morita, I.; Kobayashi, N.; Hirai, K.; Simamura, E.; Nobukawa, T.; Kadota, S. Antiallergic activity of aqueous extracts and constituents of Taxus yunnanensis. Biol. Pharm. Bull. 2006, 29, 2310–2312. [Google Scholar] [CrossRef] [PubMed]
- Banskota, A.H.; Nguyen, N.T.; Tezuka, Y.; Nobukawa, T.; Kadota, S. Hypoglycemic effects of the wood of Taxus yunnanensis on streptozotocin-induced diabetic rats and its active components. Phytomedicine 2006, 13, 109–114. [Google Scholar] [CrossRef] [PubMed]
- Hu, Y.M.; Gan, F.Y.; Lu, C.H.; Ding, H.S.; Shen, Y.M. Productions of taxol and related taxanes by cell suspension cultures of Taxus yunnanensis. Acta Bot. Sin. 2003, 45, 373–378. [Google Scholar]
- Li, S.H.; Zhang, H.J.; Yao, P.; Sun, H.D.; Fong, H.H.S. Rearranged taxanes from the bark of Taxus yunnanensis. J. Nat. Prod. 2000, 63, 1488–1491. [Google Scholar] [CrossRef] [PubMed]
- Rajana, R.; Chandranb, K.; Harperc, S.L.; Yunb, S.; Kalaichelvana, P.T. Plant extract synthesized silver nanoparticles: An ongoing source of novel biocompatible materials. Ind. Crop. Prod. 2015, 70, 356–373. [Google Scholar] [CrossRef]
- Amin, M.; Anwar, F.; Janjua, M.R.S.A.; Iqbal, M.A.; Rashid, U. Green synthesis of silver nanoparticles through reduction with Solanum xanthocarpum L. berry extract: Characterization, antimicrobial and urease inhibitory activities against Helicobacter pylori. Int. J. Mol. Sci. 2012, 13, 9923–9941. [Google Scholar] [CrossRef] [PubMed]
- Qin, Y.; Ji, X.; Jing, J.; Liu, H.; Wu, H.; Yang, W. Size control over spherical silver nanoparticles by ascorbic acid reduction. Colloids Surf. A 2010, 372, 172–176. [Google Scholar] [CrossRef]
- Singh, M.; Sinha, I.; Mandal, R.K. Role of pH in the green synthesis of silver nanoparticles. Mater. Lett. 2009, 63, 425–427. [Google Scholar] [CrossRef]
- Sankar, R.; Karthik, A.; Prabu, A.; Karthik, S.; Shivashangari, K.S.; Ravikumar, V. Origanum vulgare mediated biosynthesis of silver nanoparticles for its antibacterial and anticancer activity. Colloids Surf. B 2013, 108, 80–84. [Google Scholar] [CrossRef] [PubMed]
- Murugan, K.; Senthilkumar, B.; Senbagam, D.; Saleh, A.I.S. Biosynthesis of silver nanoparticles using Acacia leucophloea extract and their antibacterial activity. Int. J. Nanomed. 2014, 9, 2431–2438. [Google Scholar]
- Anthony, K.J.P.; Murugan, M.; Jeyaraj, M.; Rathinam, N.K.; Sangiliyandi, G. Synthesis of silver nanoparticles using pine mushroom extract: A potential antimicrobial agent against E. coli and B. subtilis. J. Ind. Eng. Chem. 2014, 20, 2325–2331. [Google Scholar] [CrossRef]
- Kim, J.S.; Kuk, E.; Yu, K.N.; Kim, J.H.; Park, S.J.; Lee, H.J.; Kim, S.H.; Park, Y.K.; Park, Y.H.; Hwang, C.Y.; et al. Antimicrobial effects of silver nanoparticles. Nanomed. Nanotechnol. Biol. Med. 2007, 3, 95–101. [Google Scholar] [CrossRef] [PubMed]
- Ruparelia, J.P.; Chatterjee, A.K.; Duttagupta, S.P.; Mukherji, S. Strain specificity in antimicrobial activity of silver and copper nanoparticles. Acta Biomater. 2008, 4, 707–716. [Google Scholar] [CrossRef] [PubMed]
- Ravishankar, R.V.; Jamuna, B.A. Nanoparticles and their potential application as antimicrobials. In Science against Microbial Pathogens, Communicating Current Research and Technological Advances; Méndez-Vilas, A., Ed.; Formatex: Badajoz, Spain, 2011; pp. 197–209. [Google Scholar]
- Gogoi, S.K.; Gopinath, P.; Paul, A.; Ramesh, A.; Ghosh, S.S.; Chattopadhyay, A. Green fluorescent protein-expressing Escherichia coli as a model system for investigating the antimicrobial activities of silver nanoparticles. Langmuir 2006, 22, 9322–9328. [Google Scholar] [CrossRef] [PubMed]
- Kanipandian, N.; Thirumurugan, R. A feasible approach to phyto-mediated synthesis of silver nanoparticles using industrial crop Gossypium hirsutum (cotton) extract as stabilizing agent and assessment of its in vitro biomedical potential. Ind. Crop. Prod. 2014, 55, 1–10. [Google Scholar] [CrossRef]
- Kanipandian, N.; Kannan, S.; Ramesh, R.; Subramanian, P.; Thirumurugan, R. Characterization, antioxidant and cytotoxicity evaluation of green synthesized silver nanoparticles using Cleistanthus collinus extract as surface modifier. Mater. Res. Bull. 2014, 49, 494–502. [Google Scholar] [CrossRef]
- Gurunathan, S.; Han, J.W.; Dayem, A.A.; Eppakayala, V.; Park, J.H.; Cho, S.G.; Lee, K.J.; Kim, J.H. Green synthesis of anisotropic silver nanoparticles and its potential cytotoxicity in human breast cancer cells (MCF-7). J. Ind. Eng. Chem. 2013, 19, 1600–1605. [Google Scholar] [CrossRef]
- Vivek, R.; Thangam, R.; Muthuchelian, K.; Gunasekaran, P.; Kaveri, K.; Kannan, S. Green biosynthesis of silver nanoparticles from Annonasquamosa leaf extract and its in vitro cytotoxic effect on MCF-7 cells. Process Biochem. 2012, 47, 2405–2410. [Google Scholar] [CrossRef]
- Remya, R.R.; Rajasree, S.R.R.; Aranganathan, L.; Suman, T.Y. An investigation on cytotoxic effect of bioactive AgNPs synthesized using Cassia fistula flower extract on breast cancer cell MCF-7. Biotechnol. Rep. 2015, 8, 110–115. [Google Scholar] [CrossRef]
- Zhang, T.L.; Wang, L.M.; Chen, Q.; Chen, C.Y. Cytotoxic potential of silver nanoparticles. Yonsei Med. J. 2014, 55, 283–291. [Google Scholar] [CrossRef] [PubMed]
- Kawata, K.; Osawa, M.; Okabe, S. In vitro toxicity of silver nanoparticles at noncytotoxic doses to HepG2 human hepatoma cells. Environ. Sci. Technol. 2009, 43, 6046–6051. [Google Scholar] [CrossRef] [PubMed]
- Kim, S.; Choi, J.E.; Chung, K.H.; Park, K.; Yi, J.; Ryu, D.Y. Oxidative stress dependent toxicity of silver nanoparticles in human hepatoma cells. Toxicol. In Vitro 2009, 23, 1076–1084. [Google Scholar] [CrossRef] [PubMed]
- Cheng, G.; Guo, W.; Han, L.; Chen, E.; Kong, L.; Wang, L.; Ai, W.; Song, N.; Li, H.; Chen, H. Cerium oxide nanoparticles induce cytotoxicity in human hepatoma SMMC-7721 cells via oxidative stress and the activation of MAPK signaling pathways. Toxicol. In Vitro 2013, 27, 1082–1088. [Google Scholar] [CrossRef] [PubMed]
- Gurunathan, S.; Raman, J.; Malek, S.N.A.; John, P.A.; Vikineswary, S. Green synthesis of silver nanoparticles using Ganoderma neo-japonicum Imazeki: A potential cytotoxic agent against breast cancer cells. Int. J. Nanomed. 2013, 8, 4399–4413. [Google Scholar]
- Faedmaleki, F.; Shirazi, F.H.; Salarian, A.A.; Ashtiani, H.A.; Rastegar, H. Toxicity effect of silver nanoparticles on mice liver primary cell culture and HepG2 cell line. Iran. J. Pharm. Res. 2014, 13, 235–242. [Google Scholar] [PubMed]
- Sperling, R.A.; Parak, W.J. Surface modification, functionalization and bioconjugation of colloidal inorganic nanoparticles. Philos. Transl. R. Soc. A 2010, 368, 1333–1383. [Google Scholar] [CrossRef] [PubMed]
- Braun, G.B.; Friman, T.; Pang, H.B.; Pallaoro, A.; de Mendoza, T.H.; Willmore, A.A.; Kotamraju, V.R.; Mann, A.P.; She, Z.G.; Sugahara, K.N.; et al. Etchable plasmonic nanoparticle probes to image and quantify cellular internalization. Nat. Mater. 2014, 13, 904–911. [Google Scholar] [CrossRef] [PubMed]
- Boca-Farcau, S.; Potara, M.; Simon, T.; Juhem, A.; Baldeck, P.; Astilean, S. Folic acid-conjugated, SERS-labelled silver nanotriangles for multimodal detection and targeted photothermal treatment on human ovarian cancer cells. Mol. Pharm. 2014, 11, 391–399. [Google Scholar] [CrossRef] [PubMed]
- Zhao, D.; Sun, X.; Tong, J.; Ma, J.; Bu, X.; Xu, R.; Fan, R. A novel multifunctional nanocomposite C225-conjugated Fe3O4/Ag enhances the sensitivity of nasopharyngeal carcinoma cells to radiotherapy. Acta Biochim. Biophys. Sin. 2012, 44, 678–684. [Google Scholar] [CrossRef] [PubMed]
- Liu, Y.T.; Li, K.; Pan, J.; Liu, B.; Feng, S.-S. Folic acid conjugated nanoparticles of mixed lipid monolayer shell and biodegradable polymer core for targeted delivery of Docetaxel. Biomaterials 2010, 31, 330–338. [Google Scholar] [CrossRef] [PubMed]
- Sun, C.; Fang, C.; Stephen, Z.; Veiseh, O.; Hansen, S.; Lee, D.; Ellenbogen, R.G.; Olson, J.; Zhang, M. Tumor-targeted drug delivery and MRI contrast enhancement by chlorotoxin-conjugated iron oxide nanoparticles. Nanomedicine 2008, 3, 495–505. [Google Scholar] [CrossRef] [PubMed]
- Zarchi, A.A.K.; Mokhtari, N.; Arfan, M.; Rehman, T.; Ali, M.; Amini, M.; Majidi, R.F.; Shahverdi, A.R. A sunlight-induced method for rapid biosynthesis of silver nanoparticles using an Andrachnea chordifolia ethanol extract. Appl. Phys. A 2011, 103, 349–353. [Google Scholar] [CrossRef]
- Geethalakshmi, R.; Sarada, D.V.L. Characterization and antimicrobial activity of gold and silver nanoparticles synthesized using saponin isolated from Trianthema decandra L. Ind. Crop. Prod. 2013, 51, 107–115. [Google Scholar]
- Zhou, Y.; Kong, Y.; Kundu, S.; Cirillo, J.D.; Liang, H. Antibacterial activities of gold and silver nanoparticles against Escherichia coli and bacillus Calmette-Guérin. J. Nanobiotechnol. 2012, 10. [Google Scholar] [CrossRef] [PubMed]
- Wang, B.J.; Won, S.J.; Yu, Z.R.; Su, C.L. Free radical scavenging and apoptotic effects of Cordyceps sinensis fractionated by supercritical carbon dioxide. Food Chem. Toxicol. 2005, 43, 543–552. [Google Scholar] [CrossRef] [PubMed]

© 2016 by the authors; licensee MDPI, Basel, Switzerland. This article is an open access article distributed under the terms and conditions of the Creative Commons Attribution (CC-BY) license (http://creativecommons.org/licenses/by/4.0/).
Share and Cite
Xia, Q.H.; Ma, Y.J.; Wang, J.W. Biosynthesis of Silver Nanoparticles Using Taxus yunnanensis Callus and Their Antibacterial Activity and Cytotoxicity in Human Cancer Cells. Nanomaterials 2016, 6, 160. https://doi.org/10.3390/nano6090160
Xia QH, Ma YJ, Wang JW. Biosynthesis of Silver Nanoparticles Using Taxus yunnanensis Callus and Their Antibacterial Activity and Cytotoxicity in Human Cancer Cells. Nanomaterials. 2016; 6(9):160. https://doi.org/10.3390/nano6090160
Chicago/Turabian StyleXia, Qian Hua, Yan Jun Ma, and Jian Wen Wang. 2016. "Biosynthesis of Silver Nanoparticles Using Taxus yunnanensis Callus and Their Antibacterial Activity and Cytotoxicity in Human Cancer Cells" Nanomaterials 6, no. 9: 160. https://doi.org/10.3390/nano6090160
APA StyleXia, Q. H., Ma, Y. J., & Wang, J. W. (2016). Biosynthesis of Silver Nanoparticles Using Taxus yunnanensis Callus and Their Antibacterial Activity and Cytotoxicity in Human Cancer Cells. Nanomaterials, 6(9), 160. https://doi.org/10.3390/nano6090160
